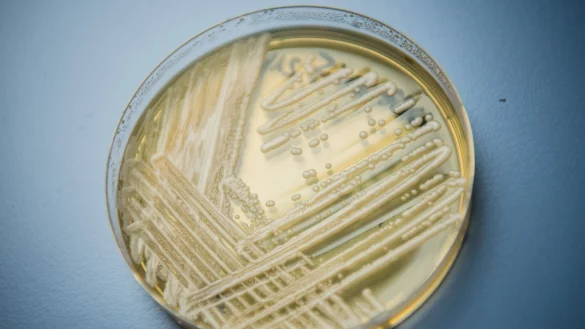
Der Hefepilz Candida auris in einer Petrischale. Die Weltgesundheitsorganisation (WHO) ist besorgt &uuml;ber 19 kranheitserregende Pilze, die nach Expertenansicht die &ouml;ffentliche Gesundheit bedrohen. - &copy; Nicolas Armer/dpa

Die Weltgesundheitsorganisation (WHO) ist besorgt über 19 krankheitserregende Pilze, die nach Expertenansicht die öffentliche Gesundheit bedrohen. Diese Erreger müssten besser erforscht werden, um Behandlungsmöglichkeiten zu entwickeln, berichtete die WHO am Dienstag in Genf.
Pilzerkrankungen seien für manche Menschen lebensgefährlich. Sie erhielten aber zu wenig Beachtung. Es sei unbekannt, wie viele Menschen betroffen seien. Die Überwachung müssen verbessert werden, aber man könne nicht warten, bis Zahlen vorliegen, warnte die WHO. Sie nennt den Pilzerreger Candida auris, der vor allem Patienten in Kliniken befällt und gegen viele Wirkstoffe resistent ist. Er wurde erst 2009 in Japan entdeckt, sei aber bereits in mehr als 50 Länder verbreitet.
«Für die meisten Pilzerreger gibt es keine schnellen und sensitiven Diagnostika, und die vorhandenen sind weltweit weder allgemein verfügbar noch erschwinglich», teilte die WHO mit. Vor allem Menschen mit Vorerkrankungen oder eingeschränktem Immunsystem bekämen leicht Pilzinfektionen, die oft spät erkannt würden und immer öfter nicht durch vorhandenen Medikamente geheilt werden können.
Gefährliche Resistenz
Pilzerkrankungen breiteten sich in der Welt zum einen durch die globale Erwärmung, die Erreger aller Art begünstige, zum anderen durch den internationalen Handel und die Mobilität vieler Menschen rund um den Globus aus. Zudem entwickelten Erreger immer öfter Resistenz zu den bekannten Wirkstoffen. Die WHO ruft Regierungen und wissenschaftliche Institutionen deshalb auf, die Laborkapazitäten zur Diagnose und Überwachung auszubauen, mehr in Forschung und Entwicklung zu investieren und mehr Aufklärung zu betreiben, um Pilzinfektionen möglichst von vornherein zu verhindern.
Die WHO hat die 19 Pilzerreger in drei Gruppen eingeteilt. Vier davon sind Pathogene, die ihrer Ansicht dringend besser erforscht werden müssten. Diese Erreger sind vor allem für Patientinnen und Patienten mit geschwächtem Immunsystem lebensgefährlich: Cryptococcus neoformans, der eine Hirnhautentzündung auslösen kann, Candida auris, der unter anderem das zentrale Nervensystem, Organe, Knochen und Augen befallen kann, Aspergillus fumigatus, der sich unter anderem in der Lunge einnisten kann, und Candida albicans. Dieser Erreger ist weit verbreutet und befällt Schleimhäute im Mund, Rachen, Genitalbereich und Darm, sorgt aber bei Gesunden kaum für Probleme. Für Immungeschwächte kann er aber lebensgefährlich werden.